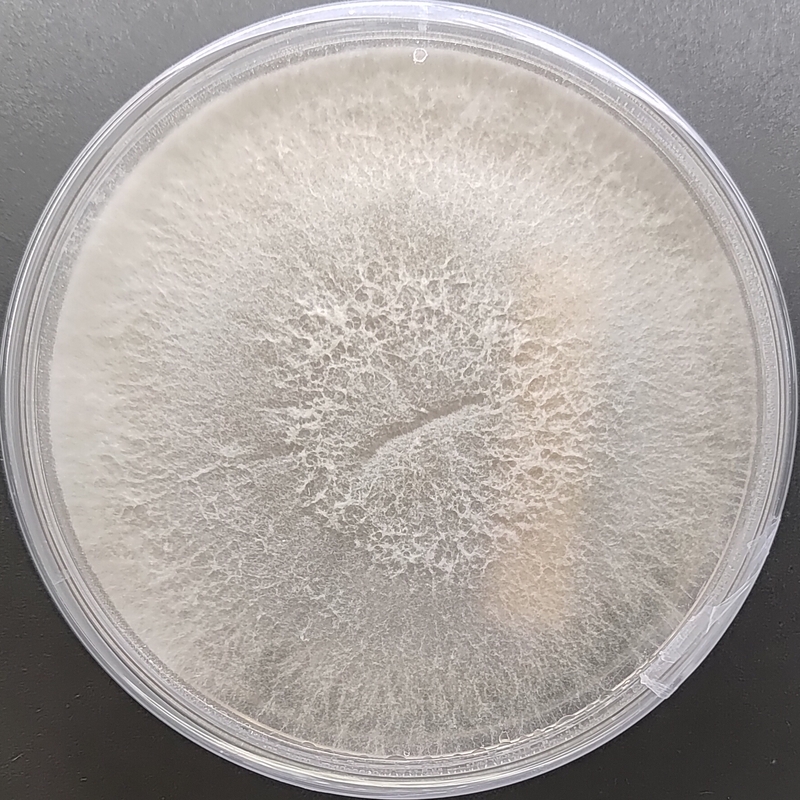

Pleurotus salmoneostramineus (Pink Oyster) Pure Culture Plate | Agripie
Introducing Pleurotus salmoneostramineus (Pink Oyster), the stunning Pink Oyster mushroom known for its vibrant color, delicate texture, and mild, seafood-like flavor. Our pure culture plates guarantee superior quality, promoting contamination-free and robust growth, ideal for both novice and seasoned mushroom cultivators.
Product Details:
Scientific Name: Pleurotus salmoneostramineus
Common Name: Pink Oyster Mushroom
Culture Type: Pure Culture Plate (Agar-based)
Quality Assurance: Lab-grown, contamination-free
Storage Recommendations: Can be stored at 4-8°C for 3 months upon receipt until use.
Benefits and Uses:
✔️ Perfect for culinary applications, especially seafood-inspired dishes
✔️ High nutritional content including essential proteins, vitamins, and minerals
✔️ Rapid and vigorous growth
✔️ Ideal for sustainable, organic cultivation
🇮🇳 Proudly produced in India by Agripie
Perfect for:
Chefs and culinary enthusiasts seeking unique mushroom varieties
Mushroom growers, research, academics and hobbyists
Advocates of sustainable agriculture and eco-friendly practices

|
| 
